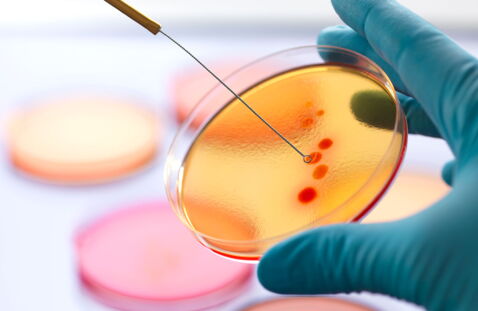
thumbnail

Die Rede ist von antibiotikaresistenten Bakterien, also Bakterien, gegen die keine Antibiotika mehr wirken. Das Problem: Die Forschung kommt nicht hinterher und braucht lange, um Studien zu belegen.
Ein Drittel der Erkrankungen erfolgen in Krankenhäusern
Seit 2007 steige die Zahl der Todesfälle stetig, so der Bericht einer internationalen Forschergruppe im Fachblatt TheLancet Infectious Diseases, welcher sich auf Daten eines europäischen Netzwerks zur Beobachtung antimikrobieller Resistenzen (EARS-Net) bezieht.
Demnach entstünden ein Drittel der Neuerkrankungen in Krankenhäusern oder anderen Einrichtung des Gesundheitssystems, so steht es in dem Bericht der renommierten Forscher-Gruppe.
In 39 Prozent der beobachteten Fälle seien die Patienten mit einem Keim infiziert, gegen den selbst Reserve-Antibiotika nichts mehr ausrichten können, was eine angemessene Behandlung nicht nur äußerst schwer, sondern teilweise auch unmöglich macht.
Anstrengungen zur Verbesserung der Situation
Um die Situation zu verbessern, seien laut der Forscher gewisse Maßnahmen nötig. So schlagen sie unter anderem vor, dass Antibiotika nur dann verschrieben und eingenommen werden sollen, wenn das wirklich unumgänglich sei.
Zudem sei es wichtig, bestehende Hygienevorschriften in Krankenhäusern unbedingt einzuhalten. Auch wenn die Forschung sich weiterhin antibiotisch wirkenden Substanzen widme, dauere es seine Zeit, bis diese auch entwickelt werden können.











